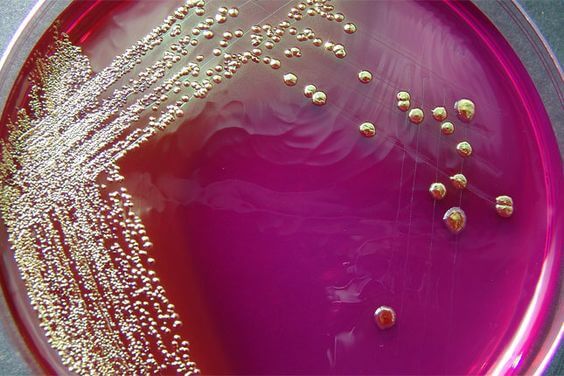
estudo microbiológico

Um estudo microbiológico pode melhorar a mastite

Em geral, a mastite é tratada efetivamente por meio de antibióticos. Mas algumas vezes as bactérias resistem ao tratamento. Para melhorar o diagnóstico de mastite, os especialistas do Departamento de Nutrição, Ciência e Tecnologia dos Alimentos da Universidade Complutense de Madri promoveram a realização de um estudo microbiológico.
A concepção dessa análise, apresentada no XI Simpósio Internacional de Amamentação Materna, pretende melhorar os quadros de mastite por meio de uma avaliação das características das bactérias que incidem em cada caso. De acordo com os especialistas, as probabilidades de sucesso de cada tratamento podem variar se for realizada uma análise microbiológica da doença com antecedência.
Os casos de mastite podem chegar a afetar até 95% das mães que amamentam se o período de aparecimento da doença for estendido para além de duas semanas. Ou seja, a maioria das mulheres no período de amamentação sofre com essa infecção antes de completar um mês amamentando.
Algumas vezes a infecção pode piorar ou não aparentar melhorias com o tratamento. Isso acontece porque as bactérias são resistentes aos antibióticos indicados. Segundo Juan Miguel Rodríguez, doutor que dirigiu a pesquisa, as bactérias relacionadas a 50% dos casos de mastite estudados apresentaram resistência ao tratamento.

Desenvolvendo um tratamento eficaz contra a mastite
Para os casos de mastite, é recorrente a prescrição de antibióticos como eritromicina e amoxicilina. No entanto, mais da metade dos casos não respondem com sucesso a esses tratamentos. Por esse motivo, os especialistas da Universidade Complutense de Madri realizaram uma pesquisa que permite afirmar que os tratamentos poderiam melhorar se fosse realizado um antibiograma e uma cultura do leite materno.
A análise proposta, além de melhorar o tratamento, também é efetiva no momento de realizar o diagnóstico. Para identificar a resistência de determinada bactéria a um grupo específico de antibióticos, é conveniente a realização do antibiograma. Isso evita a polimedicação que, algumas vezes, leva à suspensão imediata da amamentação.
Em geral, a mastite ainda não recebeu a atenção necessária há muitos anos. Em particular, devido a erros no diagnóstico e uma espécie de desvalorização da infecção. Além disso, de acordo com o doutor Rodríguez, não existe uma especialização médica em doenças relacionadas às mamas. Pois, no caso de infecções ou problemas com a amamentação, o diagnóstico fica nas mãos do ginecologista ou, inclusive, do pediatra.

De acordo com os estudos, a mastite é causada especialmente por dois grupos de bactérias: os estreptococos e os estafilococos. Estes últimos com incidência em pelo menos 75% dos quatro mil casos analisados pelos especialistas do Departamento de Nutrição, Ciência e Tecnologia dos Alimentos. As análises microbiológicas do leite materno podem ser determinantes para o diagnóstico e o tratamento eficaz da mastite. Pois permitem identificar os agentes causadores da infecção e, consequentemente, a indicação médica correspondente.
Possíveis complicações podem ser evitadas
A importância dos estudos sobre o leite materno é fundamental para que não haja consequências a se lamentar no futuro. Uma possível complicação em casos de mastite se relaciona, por exemplo, à polimedicação. Quando não tratada da maneira correta, a infecção pode causar um efeito não desejado. Ela pode acabar eliminando as bactérias do leite que não são resistentes ao medicamento, mas que também são necessárias à manutenção das propriedades do leite.
Consequentemente, na ausência de outras bactérias, o estafilococo poderia aumentar de tamanho e causar a obstrução dos canais. Outra complicação possível é a recorrência da infecção e sua transformação em uma inflamação crônica. Também foram apresentados casos nos quais a mastite provoca quadros de candidíase vaginal.
As complicações da mastite estão presentes em 10% dos casos analisados pelos especialistas, os quais garantem que tais complicações poderiam ter sido evitadas com uma simples análise microbiológica. Independentemente da gravidade dos sintomas, um diagnóstico prévio poderia fazer a diferença em relação à intensidade e à duração da infecção.
Em geral, a mastite é tratada efetivamente por meio de antibióticos. Mas algumas vezes as bactérias resistem ao tratamento. Para melhorar o diagnóstico de mastite, os especialistas do Departamento de Nutrição, Ciência e Tecnologia dos Alimentos da Universidade Complutense de Madri promoveram a realização de um estudo microbiológico.
A concepção dessa análise, apresentada no XI Simpósio Internacional de Amamentação Materna, pretende melhorar os quadros de mastite por meio de uma avaliação das características das bactérias que incidem em cada caso. De acordo com os especialistas, as probabilidades de sucesso de cada tratamento podem variar se for realizada uma análise microbiológica da doença com antecedência.
Os casos de mastite podem chegar a afetar até 95% das mães que amamentam se o período de aparecimento da doença for estendido para além de duas semanas. Ou seja, a maioria das mulheres no período de amamentação sofre com essa infecção antes de completar um mês amamentando.
Algumas vezes a infecção pode piorar ou não aparentar melhorias com o tratamento. Isso acontece porque as bactérias são resistentes aos antibióticos indicados. Segundo Juan Miguel Rodríguez, doutor que dirigiu a pesquisa, as bactérias relacionadas a 50% dos casos de mastite estudados apresentaram resistência ao tratamento.
Desenvolvendo um tratamento eficaz contra a mastite
Para os casos de mastite, é recorrente a prescrição de antibióticos como eritromicina e amoxicilina. No entanto, mais da metade dos casos não respondem com sucesso a esses tratamentos. Por esse motivo, os especialistas da Universidade Complutense de Madri realizaram uma pesquisa que permite afirmar que os tratamentos poderiam melhorar se fosse realizado um antibiograma e uma cultura do leite materno.
A análise proposta, além de melhorar o tratamento, também é efetiva no momento de realizar o diagnóstico. Para identificar a resistência de determinada bactéria a um grupo específico de antibióticos, é conveniente a realização do antibiograma. Isso evita a polimedicação que, algumas vezes, leva à suspensão imediata da amamentação.
Em geral, a mastite ainda não recebeu a atenção necessária há muitos anos. Em particular, devido a erros no diagnóstico e uma espécie de desvalorização da infecção. Além disso, de acordo com o doutor Rodríguez, não existe uma especialização médica em doenças relacionadas às mamas. Pois, no caso de infecções ou problemas com a amamentação, o diagnóstico fica nas mãos do ginecologista ou, inclusive, do pediatra.

De acordo com os estudos, a mastite é causada especialmente por dois grupos de bactérias: os estreptococos e os estafilococos. Estes últimos com incidência em pelo menos 75% dos quatro mil casos analisados pelos especialistas do Departamento de Nutrição, Ciência e Tecnologia dos Alimentos. As análises microbiológicas do leite materno podem ser determinantes para o diagnóstico e o tratamento eficaz da mastite. Pois permitem identificar os agentes causadores da infecção e, consequentemente, a indicação médica correspondente.
Possíveis complicações podem ser evitadas
A importância dos estudos sobre o leite materno é fundamental para que não haja consequências a se lamentar no futuro. Uma possível complicação em casos de mastite se relaciona, por exemplo, à polimedicação. Quando não tratada da maneira correta, a infecção pode causar um efeito não desejado. Ela pode acabar eliminando as bactérias do leite que não são resistentes ao medicamento, mas que também são necessárias à manutenção das propriedades do leite.
Consequentemente, na ausência de outras bactérias, o estafilococo poderia aumentar de tamanho e causar a obstrução dos canais. Outra complicação possível é a recorrência da infecção e sua transformação em uma inflamação crônica. Também foram apresentados casos nos quais a mastite provoca quadros de candidíase vaginal.
As complicações da mastite estão presentes em 10% dos casos analisados pelos especialistas, os quais garantem que tais complicações poderiam ter sido evitadas com uma simples análise microbiológica. Independentemente da gravidade dos sintomas, um diagnóstico prévio poderia fazer a diferença em relação à intensidade e à duração da infecção.
Este texto é fornecido apenas para fins informativos e não substitui a consulta com um profissional. Em caso de dúvida, consulte o seu especialista.







